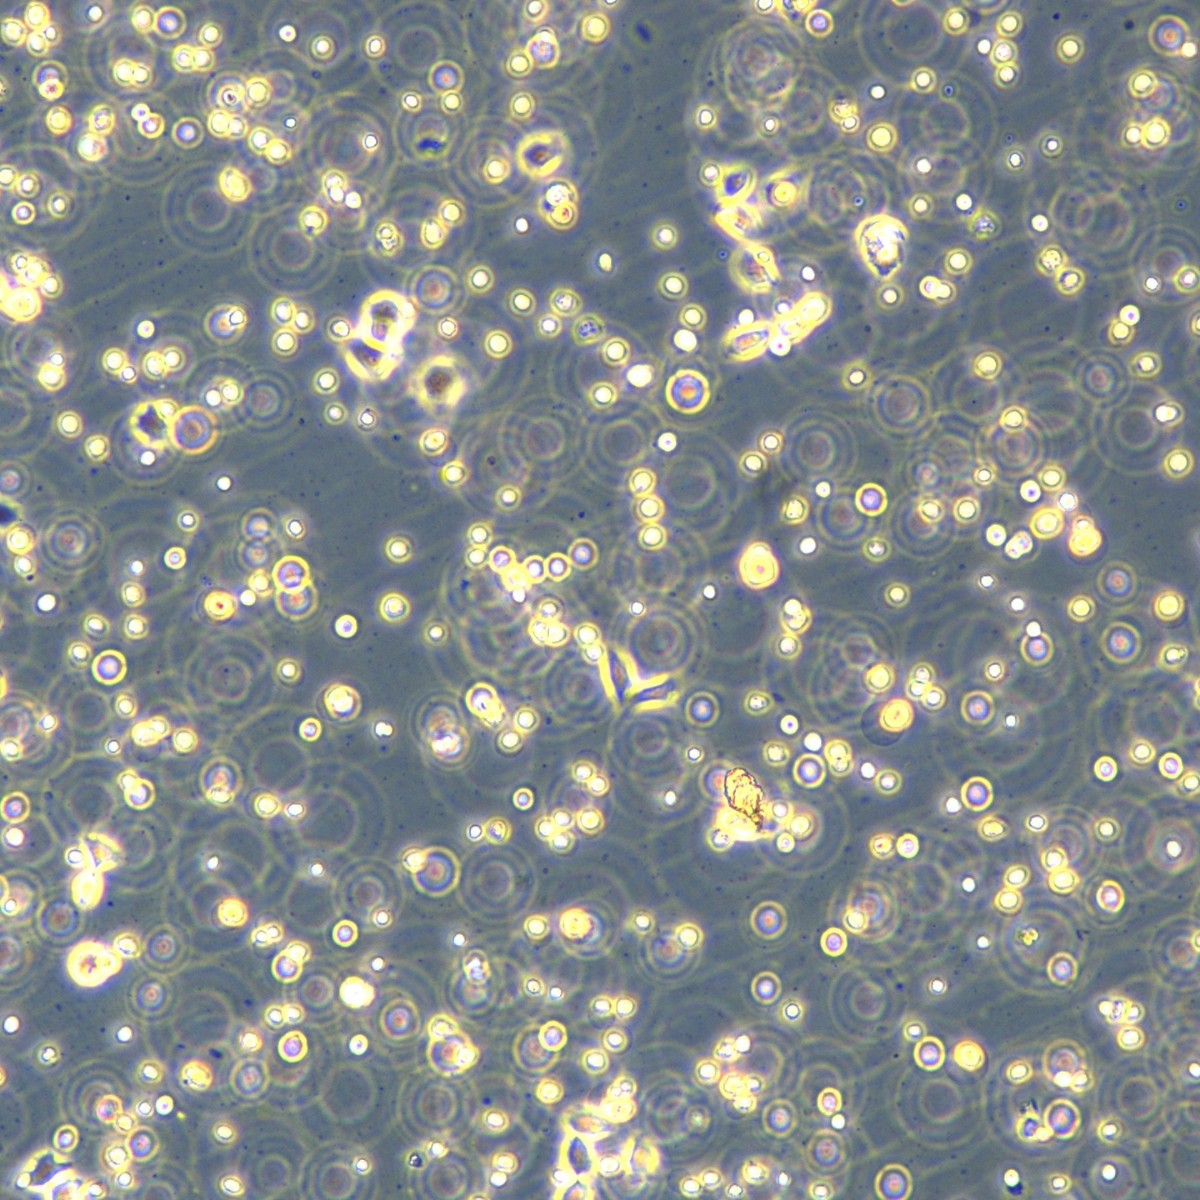
2025-09-18 14:59:32.jpg

Meisen Ctcc Meisen клетки низкодифференцированной аденокарциномы легких человека Sk-Lu-1
Цена
¥2340.00 - ¥2600.00 / ≈ 28 223 ₽ – 31 359 ₽
MOQ: 1 pcs
1шт - ¥2600.00 |2шт - ¥2470.00 |3шт - ¥2340.00
Продавец
浙江美森细胞科技有限公司
Рейтинг
0
Продано
0
Всего
В наличии
100
SKU суммарно
Offer ID: 978382173982
Оформить заказ
Характеристики:
| Изображение | Характеристики | Цена (CNY / RUB) | В наличии | SKU ID | Кол-во / Корзина |
|---|---|---|---|---|---|
📦 | 5×10⁵ | 1шт: ¥2600.00, 2шт: ¥2470.00, 3шт: ¥2340.00 | 100 | 6099589479089 |
Статистика продавца
3.5
Сервис
Источник: API 1688
3.0
Логистика
Источник: API 1688
4.0
Споры
Источник: API 1688
3.0
Оформление
Источник: API 1688
3.0
Консультация
Источник: API 1688
0%
Повторные покупки
Источник: API 1688
3.3
Постпродажное
Источник: API 1688
Свойства товара
Происхождение Jinhua, zhejiang
Нужно ли импортировать No
Класс Pharmaceutical grade
Номер товара Ctcc-400-0036
Тип Cell line
Класс продукта Qualified product
Содержание ≥ 95%
Производитель/страна происхождения Zhejiang meisen
Цель Scientific research
C.a.s Nothing
Бренд Meisen CTCC
Область применения Cell research
Специальная услуга Extra-long after-sales service, str appraisal
Название продукта Human poorly differentiated lung adenocarcinoma cells sk-lu-1
Способ оплаты Delivery upon payment
Описание товара
| 规格 | T25 |
| 货号 | CTCC-400-0036 |
| 种属 | 人源(Homo sapiens) |
| 组织来源 | 肺(Lung) |
| 疾病 | 肺腺癌(Lung adenocarcinoma) |
| 年龄 | 60岁(60 Years) |
| 培养体系 | 该细胞系培养所用基本培养基为 Dulbecco’s Modified Eagle’s Medium (DMEM), 配置完全培养基时需加入 10%FBS,1% Anti-Anti。 |
| 细胞形态 | 表皮细胞(Epithelial) |
| 生长特性 | 贴壁生长(Adherent) |
STR鉴定报告(部分)


细胞图片